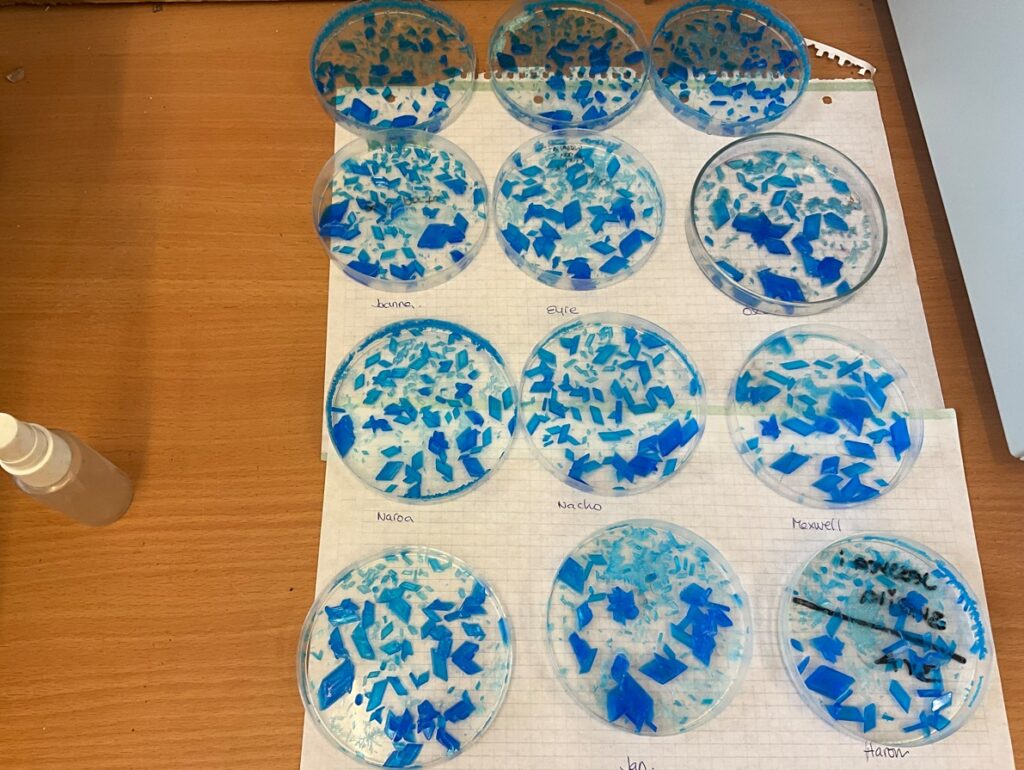

Els alumnes de 2n d’ESO han realitzat la cristal.lització del sulfat de coure (II) per així obtenir cristalls d’un blau intens i forma romboide.
Una cristal.lització és el canvi d’estat d’una substància dissolta, fosa o en un estat gasós a estat sòlid cristal.lí.
Els alumnes han practicat amb aquesta experiència dues tècniques de separació estudiades: la filtració i posterior cristal.lització.

Comentaris recents